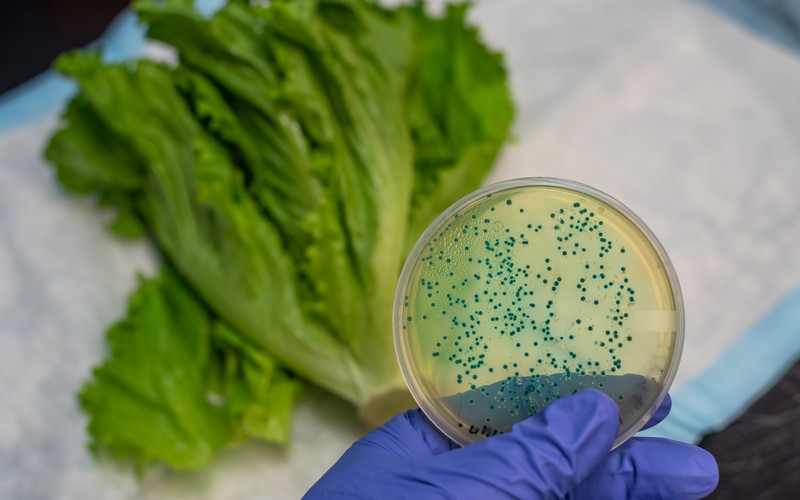
เครื่องลดความชื้นอุตสาหกรรม สำคัญอย่างไร

เครื่องลดความชื้นอุตสาหกรรม สำคัญอย่างไรสำหรับธุรกิจที่ต้องการควบคุมสภาพแวดล้อมในการผลิตและเก็บรักษาสินค้า โดยเฉพาะโรงงานและคลังสินค้าที่ต้องรับมือกับความชื้นสูงที่อาจส่งผลกระทบต่อคุณภาพผลิตภัณฑ์ ประสิทธิภาพเครื่องจักร รวมไปถึงความปลอดภัยของพนักงาน วันนี้เราจะพาคุณมาทำความรู้จักกับความสำคัญของเครื่องลดความชื้นอุตสาหกรรมและวิธีเลือกใช้ให้เหมาะสม
เครื่องลดความชื้นอุตสาหกรรม สำคัญอย่างไร
ความชื้นสูงในโรงงานและคลังสินค้าไม่ใช่เรื่องเล็กเลย เพราะนั่นสามารถส่งผลกระทบโดยตรงต่อคุณภาพสินค้า ประสิทธิภาพเครื่องจักร และค่าใช้จ่ายในการดำเนินงาน การมีเครื่องลดความชื้นที่เหมาะสมจึงเป็นการลงทุนที่คุ้มค่าสำหรับธุรกิจอุตสาหกรรมทุกประเภท และนี่คือความสำคัญของเครื่องลดความชื้นอุตสาหกรรมที่ควรรู้
ความสำคัญของเครื่องลดความชื้นอุตสาหกรรมต่อโรงงานและคลังสินค้า
- การรักษาคุณภาพสินค้าและเพิ่มอายุการเก็บรักษา เครื่องลดความชื้นช่วยสร้างสภาพแวดล้อมที่เหมาะสมสำหรับการเก็บรักษาสินค้า ลดการสูญเสียจากการเสื่อมสภาพก่อนเวลา และช่วยให้สินค้ามีอายุการเก็บรักษายาวนานขึ้น
- การประหยัดค่าใช้จ่ายในการซ่อมบำรุง การควบคุมความชื้นในระดับที่เหมาะสมช่วยลดการกัดกร่อนของเครื่องจักรและอุปกรณ์ต่าง ๆ ส่งผลให้ประหยัดค่าซ่อมบำรุงและเพิ่มอายุการใช้งานของอุปกรณ์
- การเพิ่มประสิทธิภาพการผลิต สภาพแวดล้อมที่มีความชื้นเหมาะสมช่วยให้กระบวนการผลิตเป็นไปอย่างราบรื่น ลดการหยุดชะงักจากปัญหาความชื้น และช่วยให้พนักงานทำงานได้อย่างมีประสิทธิภาพมากขึ้น
- การป้องกันความเสี่ยงด้านสุขภาพและความปลอดภัย เครื่องลดความชื้นช่วยลดการเจริญเติบโตของเชื้อราและแบคทีเรีย ป้องกันการเกิดโรคทางเดินหายใจและปัญหาสุขภาพอื่น ๆ ที่เกิดจากคุณภาพอากาศที่ไม่ดี

วิธีเลือกเครื่องลดความชื้นอุตสาหกรรมให้เหมาะสม
- พิจารณาขนาดพื้นที่และกำลังการดูดความชื้น เลือกเครื่องที่มีกำลังการดูดความชื้นเหมาะสมกับขนาดพื้นที่ใช้งาน โดยคำนวณจากปริมาตรของพื้นที่และระดับความชื้นเป้าหมาย
- ประเภทของสินค้าและกระบวนการผลิต แต่ละประเภทของผลิตภัณฑ์ต้องการระดับความชื้นที่แตกต่างกัน เช่น เครื่องสำอางต้องการความชื้น 45-55% ขณะที่ผลิตภัณฑ์โลหะอาจต้องการความชื้นต่ำกว่า 40%
- ความทนทานและการบำรุงรักษา เลือกเครื่องที่มีคุณภาพสูง สามารถทำงานได้ต่อเนื่องและมีระบบการบำรุงรักษาที่ง่าย เพื่อลดการหยุดชะงักในการผลิต
- ความประหยัดพลังงาน พิจารณาเลือกเครื่องที่มีประสิทธิภาพการใช้พลังงานสูง เพื่อลดต้นทุนค่าไฟฟ้าในระยะยาว
ปัญหาที่เกิดจากความชื้นสูงในโรงงานอุตสาหกรรม

- การเสื่อมสภาพของวัสดุและสินค้า ความชื้นสูงเป็นปัจจัยหลักที่ทำให้วัตถุดิบและสินค้าสำเร็จรูปเสื่อมสภาพก่อนเวลา เช่น การเปื่อยเน่าของวัสดุอินทรีย์ การบวมตัวของไม้ การเสียรูปของกระดาษและผลิตภัณฑ์จากไฟเบอร์ รวมถึงการเกิดรอยด่างและการเปลี่ยนสีของผลิตภัณฑ์สิ่งทอ
- การกัดกร่อนและสนิมของเครื่องจักร สภาพอากาศที่มีความชื้นสูงเป็นตัวเร่งให้เกิดการกัดกร่อนของชิ้นส่วนโลหะในเครื่องจักร ทำให้เกิดสนิมและการเสียหายของระบบไฟฟ้า ส่งผลให้ต้นทุนการซ่อมบำรุงสูงขึ้นและการหยุดการผลิตบ่อยครั้ง
- การเจริญเติบโตของเชื้อราและแบคทีเรีย ในสภาพแวดล้อมที่มีความชื้นสูง เชื้อราและแบคทีเรียสามารถเจริญเติบโตได้อย่างรวดเร็ว ส่งผลต่อคุณภาพของสินค้า โดยเฉพาะในอุตสาหกรรมอาหารและเครื่องสำอาง นอกจากนี้ยังเป็นอันตรายต่อสุขภาพของพนักงานที่ต้องทำงานในพื้นที่ดังกล่าว
สรุป
เครื่องลดความชื้นอุตสาหกรรมมีบทบาทสำคัญในการรักษาคุณภาพสินค้า ป้องกันความเสียหายของเครื่องจักร และสร้างสภาพแวดล้อมการทำงานที่ปลอดภัย การเลือกเครื่องที่เหมาะสมจะช่วยเพิ่มประสิทธิภาพการผลิตและลดต้นทุนดำเนินงานในระยะยาว ไม่ว่าคุณจะดำเนินธุรกิจด้านการผลิต คลังสินค้า หรือต้องการควบคุมคุณภาพสภาพแวดล้อมในโรงงาน DryerD พร้อมเป็นพาร์ทเนอร์ที่เชื่อถือได้ในการจัดหาเครื่องลดความชื้นอุตสาหกรรมคุณภาพสูง พร้อมทีมงานผู้เชี่ยวชาญที่มีประสบการณ์มากกว่า 5 ปี ในการออกแบบและติดตั้งระบบที่เหมาะสมกับความต้องการเฉพาะของธุรกิจคุณ
FAQ คำถามที่พบบ่อย
Q: เครื่องลดความชื้นอุตสาหกรรมสำคัญอย่างไรกับโรงงาน?
A: เครื่องลดความชื้นอุตสาหกรรมมีความสำคัญอย่างมากสำหรับโรงงานและคลังสินค้า เพราะช่วยควบคุมสภาพแวดล้อมในการผลิตและเก็บรักษาสินค้า ป้องกันการเสื่อมสภาพของสินค้าก่อนเวลา ลดการกัดกร่อนของเครื่องจักร และสร้างสภาพแวดล้อมการทำงานที่ปลอดภัยสำหรับพนักงาน
Q: ความชื้นสูงจะสร้างปัญหาอะไรให้กับโรงงานบ้าง?
A: ความชื้นสูงจะทำให้วัตถุดิบและสินค้าเสื่อมสภาพก่อนเวลา เช่น วัสดุอินทรีย์เปื่อยเน่า ไม้บวมตัว กระดาษเสียรูป และผลิตภัณฑ์สิ่งทอเปลี่ยนสี นอกจากนี้ยังทำให้เครื่องจักรเกิดสนิมและกัดกร่อน รวมถึงเป็นสาเหตุให้เชื้อราและแบคทีเรียเจริญเติบโต
Q: เครื่องลดความชื้นจะช่วยประหยัดค่าใช้จ่ายได้อย่างไร?
A: เครื่องลดความชื้นช่วยประหยัดค่าใช้จ่ายหลายด้าน ได้แก่ ลดการสูญเสียจากสินค้าเสื่อมสภาพ ประหยัดค่าซ่อมบำรุงเครื่องจักรจากการกัดกร่อน เพิ่มอายุการใช้งานของอุปกรณ์ และลดการหยุดชะงักในการผลิต ทำให้ประสิทธิภาพการผลิตสูงขึ้น
Q: จะเลือกเครื่องลดความชื้นให้เหมาะสมกับโรงงานได้อย่างไร?
A: ควรพิจารณาปัจจัยสำคัญ 4 ประการ ได้แก่
1. ขนาดพื้นที่และกำลังการดูดความชื้นที่ต้องการ
2. ประเภทสินค้าและกระบวนการผลิต เพราะแต่ละประเภทต้องการระดับความชื้นที่แตกต่างกัน
3. ความทนทานและง่ายต่อการบำรุงรักษา
4. ประสิทธิภาพการใช้พลังงานเพื่อประหยัดค่าไฟฟ้า
Q: ระดับความชื้นที่เหมาะสมสำหรับแต่ละประเภทสินค้าเป็นอย่างไร?
A: แต่ละประเภทสินค้าต้องการระดับความชื้นที่แตกต่างกัน เช่น เครื่องสำอางต้องการความชื้น 45-55% ขณะที่ผลิตภัณฑ์โลหะต้องการความชื้นต่ำกว่า 40% การเลือกระดับความชื้นที่เหมาะสมจะช่วยรักษาคุณภาพสินค้าและเพิ่มอายุการเก็บรักษาได้
Q: เครื่องลดความชื้นช่วยป้องกันปัญหาสุขภาพของพนักงานได้อย่างไร?
A: เครื่องลดความชื้นช่วยลดการเจริญเติบโตของเชื้อราและแบคทีเรียในสภาพแวดล้อมการทำงาน ป้องกันการเกิดโรคทางเดินหายใจและปัญหาสุขภาพอื่น ๆ ที่เกิดจากคุณภาพอากาศที่ไม่ดี ทำให้พนักงานสามารถทำงานได้อย่างมีประสิทธิภาพและปลอดภัยมากขึ้น
☎️ Tel: 02-906-7988, 02-033-5165
🟢 Line: @Dryer-D
📬 Email: dryer.dservice@gmail.com
📘 Facebook: เครื่องลดความชื้นและเครื่องเพิ่มความชื้น

